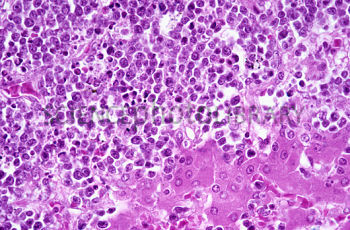

An increased number of miniaturized hairs are seen in:
1 Lichen planopilaris
2 Alopecia areata
3 Trichotillomania
4 Telogen effluvium
5 Lichen planopilaris and alopecia areata
Alopecia areata
In alopecia areata, especially early stages, increased miniaturized catagen hairs can be seen in addition to the finding of peribulbar lymphocytes resembling a “swarm of bees.” Lichen planopilaris is a scarring alopecia in which vertical tracts of fibrosis are seen in place of follicles. Trichotillomania displays follicular plugging, trichomalacia, pigmented casts, hemorrhage, and increased catagen hairs on biopsy. Telogen effluvium is characterized by an increased number of telogen hairs.

Which of the following can be used to stain amyloid?
1 PAS
2 Eosin
3 Giemsa
4 Aldehyde fuchsin
5 Crystal violet
Crystal violet
Stains for amyloidosis: Congo Red, Thioflavin T, Crystal Violet, Methyl violet, Pagoda red no. 9, PAS + diastase, amyloid P-component antibody

Which of the following would suggest a diagnosis of malignant lymphoma, B-cell type over pseudolymphoma, B-cell type?
1 Mixed-cell infiltrate
2 Mitotic figures only in germinal centers
3 Histoicytic giant cells episodically
4 Larger lymphocytes predominate
5 Prominant vasculature with thick-walled blood vessels lined by plump endothelial cells
Larger lymphocytes predominate
Histological findings in pseudolymphoma, B-cell type include a mixed-cell infiltrate (important diagnostic criterion), small lymphocytes (that predominate), the presence of histiocytes and giant cells, mitotic figures limited to the germinal centers and prominant vasculature.
Which of the following histological features would be most helpful in differentiating lichenoid drug eruption from lichen planus?
1 Civatte bodies
2 Parakeratosis and eosinophils
3 Squamatization of the basal layer
4 Presence of pruritus
5 Band-like infiltrate with Saw-tooth rete ridges
Parakeratosis and eosinophils
Lichenoid drug eruptions share clinical and histopathologic features with lichen planus. Sometimes differentiation is not possible; however, eosinophil, parakeratosis, and a deeper perivascular infiltrate is more suggestive of lichenoid drug. Implicated medications include captopril, penicillamine, and chloroquine.

Blue-gray pigmentation on the legs secondary to minocycline on biopsy stains with:
1 Fontana Masson
2 Perls
3 Sudan black
4 Fontana Masson and Perls
5 All of these answers are correct

Fontana Masson and Perls
There are three types of pigmentary change that are caused by minocycline. The blue-gray pigmentation on the legs and the blue pigment in scars is thought to be secondary to a drug-protein complex deposited in the dermis. The blue-gray pigment on the legs stains with Perls and Fontana-Masson. The blue in scars (often on the face) stains with Perls. The muddy-brown discoloration on sun-exposed areas shows increased basilar pigment and melanin incontinence on biopsy. It is likely secondary to phototoxicity.

Eccrine glands are found on the:
1 Labia majora
2 Labia minora
3 Glans
4 Prepuce
5 Vermilion

Eccrine glands are present all over the body except on the vermilion of lips, glans, labia minora, nail beds, and inner prepuce.

Paraproteinemia is associated with all except:
1 Scleromyxedema
2 Necrobiotic xanthogranuloma
3 Scleredema
4 Sclerosing panniculitis
5 Plane xanthoma

Sclerosing panniculitis Sclerosing panniculitis (lipodermatosclerosis) displays characteristic changes in the fat (lipomembranous change); it is not associated with paraproteinemia. Generalized plane xanthomas, scleromyxedema, necrobiotic xanthogranuloma, scleredema, erythema elevatum diutinum, xanthoma disseminatum, and pyoderma gangrenosum have all been associated with a paraproteinemia.
Pic: Erythema Elevatum Diutinum
Paraproteinemia, or monoclonal gammopathy, is the presence of excessive amounts of a single monoclonal gammaglobulin (in this case denominated “paraprotein”) in the blood. It is usually due to an underlying immunoproliferative disorder.
Paraproteinemias may be categorized according to the type of monoclonal protein found in blood:
Light chains only (or Bence Jones protein). This may be associated with multiple myeloma or AL amyloidosis.
Heavy chains only (also known as “heavy chain disease”);
Whole immunoglobulins. In this case, the paraprotein goes under the name of “M-protein” (“M” for monoclonal). If immunoglobulins tend to precipitate within blood vessels with cold, that phenomenon takes the name of cryoglobulinaemia.
The three types of paraproteins may occur alone or in combination in a given individual. Note that while most heavy chains or whole immunoglobulins remain within blood vessels, light chains frequently escape and are excreted by the kidneys into urine, where they take the name of Bence Jones protein.
It is also possible for paraproteins (usually whole immunoglobulins) to form polymers by aggregating with each other; this takes the name of macroglobulinemia and may lead to further complications. For example, certain macroglobulins tend to precipitate within blood vessel with cold, a phenomenon known as cryoglobulinemia. Others may make blood too viscous to flow smoothly (usually with IgM macroglobulins), a phenomenon known as Waldenström macroglobulinemia.

Methyl-green pyronin stains RNA what color?
1 Pink
2 Green
3 Blue
4 Purple
5 Black
Pink
Methyl-green pyronin stains RNA pink and stain DNA green.

What is this neoplasm?
1 Hibernoma
2 Malakoplakia
3 Myospherulosis
4 Liposarcoma
5 Pleomorphic lipoma

Hibernoma
Hibernoma: This is a rare neoplasm that typically occurs in 30-40 year old males as a slowly enlarging warm mass on scapular region, trunk, axilla or thigh. There are also myxoid & spindle cell variants that occur on the posterior neck/shoulder. The lesion enhances with contrast on CT and MRI fails to reveal fat septations which differs for that seen with other lipomas. Abnormalities in 11q13 and loss of MEN1 gene on 10q22 have been noted. Histologically: The lesion is composed of large polygonal adipocytes that have with multiple vacuoles and an eosinophilic granular cytoplasm with a central nucleus and prominent nucleolus. These cells are referred to as “Mulberry cellsâ€. Admixed among these larger adipocytes are smaller cells with a granular cytoplasm, mature white fat and some times spindle cells.

This is associated with MEN IIa:
1 Neurothekeoma
2 Macular amyloidosis
3 Malignant peripheral nerve sheath tumor
4 Chondroid syringoma
5 Mucocele

Macular amyloidosis
Macular amyloidosis is associated with MEN IIa.

Multiple clear cell acanthomas are associated with:
1 Ichthyosis
2 Cowden’s
3 Immunosuppression
4 Gastrointestinal polyps
5 Breast cancer

Ichthyosis
Clear cell acanthoma is associated with ichthyosis.

Which of the following is characteristic of Birt-Hogg-Dube Syndrome?
1 Autosomal recessive mode of inheritance
2 Multiple trichoepitheliomas
3 Caused by mutation in hamartin
4 Multiple trichodiscomas
5 Colon cancer common

Multiple trichodiscomas
Birt-Hogg-Dube Syndrome (BHD) characterized by multiple small harartomas of mesodermal component of hair discs, which were indentified as trichodiscromas. It is an autosomal dominant disease caused by mutations in folliculin. Patients with multiple fibrofolliculomas may also have acrochordons, collagenomas, lipomas, and/or oral fibromas. BHDS recently has been reported in association with various types of renal tumors, such as oncocytoma and a variant of papillary renal cell carcinoma. There are no trichoepitheliomas in BHD syndrome.
Think of a Hog & Disc!!
TRICHODISCOMA
Trichodiscoma usually occurs as multiple dome-shaped papules a few millimeters in diameter. They occur either localized to one area, widely distributed, or in association with multiple fibrofolliculomas on the face and neck (Birt-Hogg-Dubé syndrome). Trichodiscoma is hypothesized to be derived from the hair disc (Haarscheibe).
Trichodiscoma: Dome-shaped papule with thinned epidermis and moderate increase in papillary dermal connective tissue. Note normal epidermis and dermis on the extreme left. (Scanning power)
Fine fibrillar connective tissue contains superficial thick-walled blood vessels with small lumina (Fig. 34-87)
Mild interstitial mucin deposition among fine collagen bundles (Fig. 34-88)
DDX:
Small angiofibroma (fibrous papule) may resemble trichodiscoma; mild perifollicular fibrosis and stellate cells favor angiofibroma.

Which fixative would best preserve the histologic features of a gout tophus?
1 Saline
2 Absolute ethanol
3 Formaldehyde
4 Michel’s fixative
5 Tissue culture media

Absolute ethanol
Gout tophi are caused by deposition of monosodium urate monohydrate crystals. Using absolute ethanol to fix the biopsy specimen will preserve the crystalline architechture. In formaldehyde fixed tissure, the crystals are less obvious.

Which of the following is sometimes used to stain BCC during Mohs micrographic surgery?
1 Carcinoembryonic Antigen
2 Factor 13A
3 Glial Fibrillary Acidic Protein
4 Desmin
5 Toluidine Blue

Toluidine Blue
The correct answer is toluidine blue. Toluidine blue staining shows dark blue BCC tumor cells and a magenta-colored stroma around the tumor cells. CEA is used to stain adenocarcinoma, extramammary Paget's disease, and eccrine neoplasms. Desmin stains muscle. GFAP stains neurologic cells including astrocytes and Schwann cells. Factor 13A is used to stain dermatofibroma.

Weibel-Palade bodies are seen in:
1 Endothelial cells
2 Spitz Nevi
3 Cells infected with MCV
4 Plasmacytoid Cells
5 Malakoplakia

Endothelial cells
Weibel-Palade bodies are seen in endothelial cells and are therefore found in vascular lesions. Kamino bodies are found in Spitz nevi. Henderson Patterson bodies are seen in molluscum. Dutcher bodies are intranuclear inclusions seen in plasmacytoid cells. Michaelis Gutmann bodies are partially digested bacteria seen in malakoplakia.

What is your best diagnosis?
1 Lichen Trichophyticus
2 Secondary Lues
3 Lichen Nitidus
4 Scabies
5 Acral Hyperkeratosis

Lichen Nitidus
A chronic inflammatory disease characterized by shiny, flat-topped, usually flesh-coloured micropapules no larger than the head of a pin. Lesions are localized in the early stages, found chiefly on the lower abdomen, penis, and inner surface of the thighs. Distribution may become generalized as the disease progresses.
The predominant location of the cleft in erythema toxicorum neonatorum is:
1 Dermal
2 Basement membrane zone
3 Basal keratinocytes
4 Suprabasal
5 Subcorneal/granular

Subcorneal/granular
Erythema toxicorum neonatorum is an idiopathic vesiculopustular eruption on the face and trunk of neonates that often resolves in a few weeks. Histologically it presents with subcorneal eosinophil rich pustules.

This tumor was excised from the scalp of an older woman, what is this neoplasm?
1 Cylindroma
2 Sebaceous carcinoma
3 Pilomatricoma
4 Basal cell carcinoma
5 Spiradenoma

Cylindroma
Cylindroma: Most often seen in middle age females on the scalp. Multiple lesions can be associated with trichoepitheliomas, spiradenoma and adenomas of parotid gland in Brooke Spieler syndrome. Histologically this is a poorly circumscribed dermal tumor with multiple small irregularly shaped basophilic islands often likened to puzzle pieces composed of a peripheral layer of smaller darker cells, with cells that have increased eosinophilic cytoplasm centrally. Each island is surrounded by a thick eosinophilic cuticle (type IV and VII collagen), with similar eosinophilic hyaline droplets seen within the island.

This lesion was excised from the face, what is this neoplasm?
1 Clear cell syringoma
2 Sebaceous carcinoma
3 Microcystic adenocarcinoma
4 Renal cell carcinoma
5 Clear cell hidradenoma

Clear cell syringoma
Syringoma: Multiple eyelids, cheeks, chests, can be eruptive and increased numbers in Down’s syndrome and a clear cell change has been associated with Diabetes. Histologically this is a dermal tumor consisting of eccrine ducts, lined by two cell layers sometimes creating a tad pole appearance, there can also be small basaloid islands or strands of cells. Within the lumens of the ducts is eosinophilic material, the lumens are CEA+. The tumor is located superficially and fails to display perineural extension as is seen in MAC. The glands are associated with a fibrous sclerotic stroma, usually no (or minimal) keratin cysts or foreign body granulomas as seen in desmoplastic trichoepithelioma. Enlargement of the glandular cells more of a clear or vacuolated cytoplasm can be seen in patients with diabetes.
Syringomas arise from or recapitulate the intradermal eccrine duct and usually occur as multiple 1 to 3 mm periorbital papules (Fig. 33-50, 33-51, 33-52). They are most commonly symmetrically distributed although rarely in a linear pattern. They appear at puberty or during young adult life and are seen in nearly one in five individuals with trisomy 21 (Down’s syndrome). They occasionally appear on the neck, trunk, axillae or genitalia and are rarely solitary. They may appear in successive crops as eruptive syringoma (Fig. 33-53).
MICROSCOPIC FEATURES:
Short epithelial strands with occasional ducts and ectatic ducts or microcysts in a fibrotic stroma in the superficial reticular dermis or papillary dermis (Fig. 33-54)
Ectatic duct may have epithelial extension giving the characteristic comma-shaped duct (Fig. 33-55,33-57) or “tadpole” sign (Fig. 33-55,33-56).
Ducts are composed of two cell layers of flattened epithelial cells (Fig. 33-57).
Fine eosinophilic granular material within the ducts (Fig. 33-57)
Superficially the ectatic ducts will often keratinize and form milia.
Clear cell syringoma is a variant with two to several layers of pale highly glycogenated or vacuolated duct cells (Fig. 33-58).
May be seen in association with intradermal nevi as an incidental finding
DIFFERENTIAL DIAGNOSIS:
Fibrotic stroma, irregular epithelial strands and occasional keratin cyst formation seen in syringoma may be difficult to separate from desmoplastic trichoepithelioma that can be excluded by lack of eccrine ducts.
Fibrosing or morphea-form basal cell carcinoma may appear similar to a syringoma; presence of ducts or lack of nuclear atypicality point to syringoma.
Lack of deep reticular dermal or subcutaneous involvement by the epithelial strands or cysts help in excluding microcystic adnexal carcinoma.

All of the following are true regarding smooth muscle hamartomas except:
1 Hyperpigmentation
2 Transient piloerection
3 Hypertrichosis
4 Association with “Michelin tire baby” in females
5 Becke’s nevus is an example

Association with “Michelin tire baby” in females
Smooth muscle hamartomas of the skin may develop from three locations: the arrector pili muscles, blood vessel walls, and genital/areolar skin. The have been associated with hyperpigmentation, tranisent piloerection (“pseudo-Darier’s sign”) and hypertrichosis. It is thought to be the underlying lesion in “Michelin tire baby” syndrome in boys, not girls.

The mutated product in Darier’s disease is:
1 SPINK5
2 SERCA2
3 ATP2A2
4 ATP2C1
5 SPINK5 and ATP2A2
SERCA2
In Darier’s disease, the ATP2A2 gene encoding the SERCA2 Ca(2+)-ATPase is mutated in some patients. SPINK5 is the gene that is mutated in some patients with Netherton’s syndrome, and this gene the serine protease inhibitor LEKTI. ATP2C1 is the gene mutated in some patients with Hailey-Hailey disease.
2 Headed Shark eating a Dairy Cow!

The organisms highlighted by this GMS stain are?
1 Blastomycosis
2 Coccidioidomycosis
3 Mucormycosis
4 Candida albicans
5 Histoplasmosis capsulatum

Blastomycosis
Blastomycosis: Gilchrist disease, Bird droppings or spores on wood along Mississippi basin, incubation 33-44 days. Most infections develop in previously healthy people. In patients with HIV, 46% will get CNS symptoms, which is 5-10x greater than non-HIV pts. 4 forms, pulmonary, disseminated (CNS, bone, skin and GU) with secondary cutaneous lesions and primary inoculation (rare-1-2 weeks after exposure-sporotrichoid pattern- mixed infiltrate numerous budding organisms). Lesions more typically are verrucous or ulcerated plaques in males on exposed skin-face. Histology: Pseudoepitheliomatosis hyperplasia overlying acute dermal inflammation usually only a few organisms in center of abscess with thick walled 7-15 microns, single broad based bud, has a WI-1 adhesion protein and are best seen with PAS or GMS.

Which of the following does not stain for mucopolysaccharides (mucin)?
1 Periodic-acid Schiff (PAS)
2 Trichome
3 Alcian blue
4 Colloidal iron
5 Mucicarmine
Trichome
Trichome does not stain acid mucopolysaccharides. Trichome stains collagen blue or green and muscle red depending on reagents used. PAS stains mucopolysaccharides red, alcian blue stains mucopolysaccharides blue, colloidal iron stains mucin blue and mucicarmine stains mucin red.

This was a deep seated large tumor in the thigh, what is it?
1 Liposarcoma
2 Nodular fascitis
3 Hibernoma
4 Spindle cell lipoma
5 Pleomorphic lipoma

Liposarcoma
A liposarcoma is one of the most common sarcomas to occur in adults, 50-70yos. Those that occur in resectable regions (like the thigh) have a good prognosis; those that occur in retroperitoneum, mediastinum or spermatic cord recur repeatedly and have a risk to dedifferentiate with a mortality approaching 80% over the following 10-20 years. It has a characteristic supernumerary ring with amplification of 12q14 MDM2 region. Histologically The adipocytes vary in size throughout the tumor. Pleomorphism is variable depending upon the degree of differentiation that the tumor displays. The nuclei of the more well-differentiated adipocytes, as well as, the spindled cells are hyperchromatic with nuclear atypia. The presence of lipoblasts, i.e. either mono-vacuolated signet ring type of lipoblast as is more commonly seen in myxoid liposarcoma and/or multi-vacuolated lipoblasts with central nuclei scalloped by vacuoles, are characteristic of a liposarcoma, but are not necessary to make the diagnosis. There is often a plexiform proliferation of blood vessels, with an appearance that has been likened to crow’s feet or chicken wire. The stroma can be loose and delicate, fibrous or myxoid. Thick ropey fibrous septae are common in liposarcoma and in lipoblastoma.
The majority of liposarcomas are found in the deep soft tissues, particularly the thigh muscles, and only a very small proportion arise in the subcutaneous fat (Fig. 37-38). However, liposarcoma arising from muscle may extend along fascia and into the subcutaneous fat. The tumor may be aggressive and exhibit metastases to lung and liver. Early wide excision is necessary for cure of these aggressive lesions (Fig. 37-39,37-40).
At least four types of liposarcoma have been characterized with different histologic features, age predominance, and prognosis. They are 1) well-differentiated, 2) myxoid, 3) round cell and 4) pleomorphic. More than one subtype may be seen in a tumor. Well-differentiated tumors are often seen in the elderly and may be subdivided into a) “lipoma like”, b) inflammatory and c) sclerosing, all of which are low grade and show occasional recurrences but no metastases. Well-differentiated tumors in the subcutis are cured by simple excision and the term atypical lipoma or atypical lipomatous tumor has been introduced. The myxoid variants are typically seen in younger individuals and also have a better prognosis. Pleomorphic liposarcomas appear in the elderly and have a worse prognosis.
MICROSCOPIC FEATURES:
Common denominator for the diagnosis of all subtypes of liposarcoma is identification of lipoblasts, age of the patient, location of tumor, poor circumscription with infiltration or replacement of normal muscle, fascia, or adipose tissue.
Variable cellularity but usually some areas with high cellularity (Fig. 37-41)
Lipoblasts exhibit characteristic sharply demarcated vacuole or several vacuoles within the cytoplasm of a spindle cell or ovoid cell that indents the nucleus (Fig. 37-42,37-43).
Fat stains of frozen sections or alcohol prepared, non-extracted specimens may reveal subtle (Fig. 37-44) to marked lipid content (Fig. 37-45).
Nuclear hyperchromasia, pleomorphism and atypical mitoses in lipoblasts are variable, depending on tumor subtype.
Well-differentiated liposarcoma (deep tissues) or atypical lipoma (subcutaneous primary lesion) exhibit broad fibrous septa dividing mature adipose tissue but containing lipoblasts.
Well-differentiated liposarcoma and atypical lipoma exhibit lipoblasts and mature adipocytes, with mild hyperchromasia and mild pleomorphism.
Myxoid liposarcoma shows lipoblasts, myxomatous loose collagenous stroma (Fig. 37-46) and a plexiform capillary pattern (Fig. 37-47).
Well-differentiated variant of myxoid liposarcoma with better prognosis is composed of signet ring cells.
Poorly differentiated variant of myxoid liposarcoma exhibits large, pleomorphic nuclei and lipoblasts with fewer and smaller vacuoles.
Round cell liposarcoma is more densely cellular with uniform round to oval cells with scant glycogenated cytoplasm as confirmed by diastase sensitive PAS staining.
Round cell liposarcoma has cells with small vacuoles and both these and the round cells show nuclear atypicality and numerous mitoses.
Transition areas to other subtypes often help identify lipoblasts in round cell liposarcoma.
Pleomorphic liposarcoma contains lipoblasts with marked pleomorphism (Fig. 37-48,37-49) and bizarre giant cells (Fig. 37-50).
Some tumors may exhibit regions of hypocellularity (Fig. 37-51) with atypical multinucleated lipoblasts (Fig. 37-52), hypercellularity (Fig. 37-53) with numerous mitoses (Fig. 37-54), and rare bizarre giant cells (Fig. 37-55).
Abrupt transitions from cellular to myxoid areas are seen (Fig. 37-56,37-57).
DIFFERENTIAL DIAGNOSIS:
Several mesenchymal and neural tumors may exhibit atypical vacuolated cells or myxomatous features; immunohistochemistry panels are necessary to help discriminate between them.
Liposarcoma and the following tumors are positive for vimentin; other markers (in parentheses) help identify the other mesenchymal tumors, namely malignant schwannoma (S-100 protein), leiomyosarcoma (desmin), rhabdomyosarcoma (myoglobin) and malignant fibrous histiocytoma (α-1-antichymotrypsin and α-1-antitrypsin).
Cutaneous extraskeletal Ewing’s sarcoma (primitive neuroectodermal tumor) resembles round cell liposarcoma due to round cell morphology with abundant cytoplasmic glycogen; immunohistochemical staining for neuron specific enolase, S-100 protein and leu 7 helps identify Ewing’s sarcoma.
Poorly differentiated metastatic adenocarcinoma of the kidney or adrenal gland exhibit lipid vacuoles and are important to differentiate from liposarcoma, particularly round cell variants that may show pseudoglandular features. This is most important in the retroperitoneum, but metastatic lesions to skin may present a differential; immunohistochemical positivity for vimentin and focal low-molecular weight cytokeratins following proteolytic digestion favor adenocarcinoma or cortical carcinoma.
Metastatic gastric signet ring carcinoma may resemble vacuolated lipoblasts; intracellular sialomucin and cytokeratin positivity are seen in this tumor.
Benign lipoblastoma may be extremely difficult by histology alone to differentiate from liposarcoma; however, the young age of the patient, location of the lesion and lack of mitoses permit a benign diagnosis.
